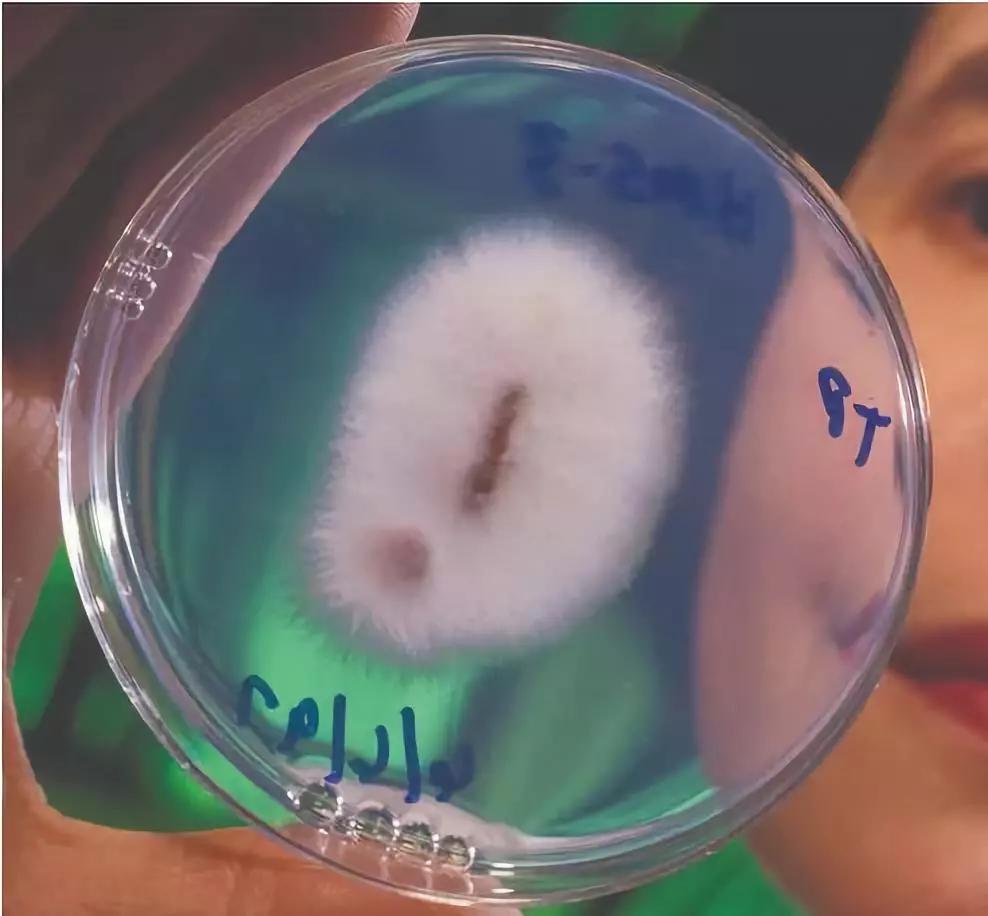
警惕病毒次生危害,警惕多种病毒一并来袭

这次的疫情让人们对病毒有了更加深刻的认识,但是,我们不仅要警惕动物病毒,更要重视植物病毒,因为植物病毒引起的农业危机会给人类带来更大灾难,这在历史上是已经多次发生过了的,本文以人类文明发展的脉络去重新理解我们和自然的关系,以爱尔兰土豆大饥荒为例子,谈谈单一培育的农作物带来的繁荣是多么脆弱,希望能够唤起人们对生态多样性的重视,呼吁大家重视对自然的保护。
一,农耕增加生产,可生物多样性的丧失给我们带来危机
人类创造出了多姿多彩的文化,而人类最早期,最典型的文化创造的体现就是人类的“劳动”,即培育选种和种植,种田就是文化,为什么?因为动物不会自己给自己种田,自然界中本来也没有农田,这是人为创造。
比如,粮食作物以及瓜果蔬菜在自然界中是很小的,产量也很低,我们今天看到吃到的这么大的、这么好吃的水果都是人工培育选种的,比如麦子,麦子最原始的时候都是成熟了要爆开,传播种子,可是它爆开了人类却不方便收集,于是人类就找那种成熟了后不爆开的麦子作为选种进行培育,于是你今天看到的全是当初本来不占繁衍优势的麦子的后代。这都是人为进行的创造,这都叫文化,中华文化的底层逻辑就是农耕文明。

但是,这份人为的创造一方面让我们吃得饱穿得暖,但是另外一方面也带来了更大的危机!比如农作物带给我们的文明病,如小麦等作物使我们改变最原始的摄取能量的方式,今天的糖尿病即是人类吃这类作物易发胖所导致的。
这不是今天要谈的重点,我们今天谈的是农作物因为人类的单一培育,使得物种多样性丧失之后,一旦遇到病毒,立刻出现危机,比如香蕉,原始香蕉内部全是种子,没法吃,而人工筛选培育解决了这一问题,将无籽香蕉的后代单一栽培基因是一样的,所以你吃各地香蕉感觉味道都差不多,长期单一栽培的结果就是基因遗传多样性的丧失,香蕉的品系越来越单一。
现在香蕉已经高度雌雄不育了,而这就造成一个问题,别看全球大部分地区都有种植,一旦出现可怕的病毒,全军覆没的几率非常大,这就是今天人类为什么要保持生物多样性和基因多样性的原因,单一品系的存亡危机始终存在,人类的担心就是:那些对香蕉致命的病菌和病毒同样也在演化和潜伏,它们也在和人类科技手段的进步拼比时间。人类对病毒真的是知之甚少。

被病毒侵入而枯死的香蕉看上去就是这样的
二,人类文明发展帮助病毒进化
举个例子:艾滋病毒HIV本来是没有的,它是由猿猴种群类的一种叫做SIV特异病毒变异过来的,SIV(猴免疫缺陷病毒)变异且冲破种群间的屏障传染给人类的,能够适应人类的身体环境且能生存复制,最终发展成为其他亚型。这个东西是专门针对人类的,有人会说,艾滋病现在不快被攻破了吗?怕什么。

可这表示未来不会出现更可怕的病毒吗?这次病毒的变异我们是亲眼所见,所以,人类永远是动用巨量的资源拼命追着去解决问题的,可病毒只需要依靠本能变异就行了,所以这场比赛很难跑得赢。
比如,过去原始时期的动物病毒不像今天这样可怕,具有高传染性和*爆高**发性,为什么?因为那时候无论人群还是动物种群,密度都比较低,病毒如果像今天这样爆发和传染的如此迅速,它活不下去,而今天病毒之所以能在种群内迅速的传播和爆发,因为人类种群密度越来越高,所以它不需要像过去那样一直潜伏着了,这就是它的一个变异,这个变异过程只需要不能,细菌有科学吗?没有。
我们从这个过程中发现什么?人造物反而会使得这些改变了自然环境的东西作用于自己身上,糖尿病怎么来的?就是我们改变自己的饮食而来的,这是不是很奇妙的关系?
三,历史中的香蕉危机、咖啡树危机
你可能会说病毒这事情发生在香蕉的身上几率小,香蕉的上一代中有个叫大麦克品种据说香味异常浓郁特别好吃,1890年遇到了巴拿马病,几乎全部死亡,只有一小部分转移到了美洲得以幸存,为什么人类斗不过香蕉病毒?因为香蕉被人类培育成了无性繁殖,研究人员无法通过遗传变异的手段发展出对疾病的抗株,所以蕉农们只能眼睁睁地看着大片香蕉林枯死,却什么也做不了。现在我们吃的都是卡文迪许香蕉,简称华蕉,一旦未来再遇到病毒会是如何后果?
巴拿马病毒,又名有名香蕉枯萎病1号,致病菌为尖孢镰刀菌古巴专化型。

19世纪初,英国殖民地锡兰是主要的咖啡种植地,巨大的需求让这个地方密密麻麻地种满了同一种咖啡树。但一场咖啡叶锈病席卷整个锡兰,一棵树倒下了意味着所有咖啡树死亡。

咖啡叶锈病(Hemileia vastatrix),也常被称作罗亚,是一种疾病,可以摧毁种植园和咖啡树,不幸的是咖啡叶锈病成为一个世界性的问题。下面我们以历史中爱尔兰土豆大饥荒举例分析。
四,土豆是怎么从美洲走向欧洲的
美国是多民族移民国家,白人中最多的是英国、德国和爱尔兰人的后裔。这当中,爱尔兰人大概有三千多万人,你会觉得很奇怪,因为爱尔兰是一个很小的国家,现在只有四百万人口,可是美国的爱尔兰裔居然有这么多人,解释这个问题,还得从一种非常普通的农作物说起,那就是土豆。
地理大发现之后,各大洲的人开始迁入美洲。但是,交流都是双向的,从美洲到世界各地的更多的就是农作物,美洲的农作物使得全世界的国家人口开始暴增,这其中包括中国的清朝,如今很多常见的农作物都是从美洲传过来的,比如玉米、番薯、花 生、辣椒、南瓜和西红柿,当然,还有土豆。

土豆最开始是生长在南美洲的,后来被西班牙人给带到了欧洲,最开始人们是很难接受这种长在土里的东西,因为土豆外表坑坑洼洼,很像麻风病人的脸,所以 欧洲的农民认为它有毒,不敢种。但是没过多久,人们就知道这个作物的神奇,它适应环境的能力很强,不怎么需要浇水施肥,除了盐碱地之外,种哪都可以,而且又没有固定的收荻期,可以随时从地里挖出来吃,这也就是过去中国西北地区的人,如果这个地区的人特别喜欢吃土豆,原因是地理环境等条件相对匮乏,所以土豆是主食,这一点和欧洲的情况是一样的,当然,现在物流发达,什么东西都是很常见的,比如前段时间西北春天的时候就有缅甸的西瓜可以吃。

种植土豆
当时欧洲各国经常遭受饥荒的威胁,这简直就是一种恩赐。法国启蒙思想家狄德罗就说过,土豆虽然吃起来没什么味道,但如果你只饱肚子的话,倒挺合适的,这是欧洲人做土豆的方式不多,常见的就是土豆泥和饼,可要是中国人做土豆,那是各种花样和口味。
在荷兰,一开始人们把土豆当作小麦的补充,种得还不多。可到了1740年,欧洲的特别冷,中国是清高宗乾隆五年,小麦不耐寒,收成大减,而土豆耐寒,收成没减,于是荷兰人赶紧在国内推广土豆。
德国也是一样。当时的德国经常陷入战争,一打起仗来,士兵走到哪里就在哪里找东西吃,麦田很容易就被糟蹋,但是土豆长在地下,当时的人还不太知道这个东西,于是大家都种土豆,可是后来士兵也知道了,但土豆此时已经成为德国粮食种植最多的了,就这样到了18世纪末期,欧洲大部分地区基本都种土豆。当时1779年还爆发一场被称作“土豆战争”的历史故事,就是因为双方交战时间太长,最后的军粮就是四处去挖土豆。
五,土豆养活了爱尔兰人
在所有这些国家里,爱尔兰是对土豆依赖最严重的国家,因为爱尔兰是岛屿国家,降雨量很大,纬度很高,所以光照不足。由此形成的土壤条件和气候条件不太适都小麦,小麦特别需要光照,而不太需要水,可是这样的环境异常适合种土豆。

据科学网的数据,在爱尔兰,种小麦的话,每亩地每年的收成只有三四百斤,而种土豆的收成却可以达到1吨。土豆能养活更多的穷人。
土豆在爱尔兰种得多,还有一个原因,就是英国的统治。当时,爱尔兰是英国的殖民地。爱尔兰的绝大部分土地都被英国地主占了。到了 1714年,掌握在爱尔兰人手中的土地只剩下7%。
这样一来,大部分爱尔兰人就只能去租英国地主的土地。由于人多地少,贫穷的爱尔兰农民只能依靠租来的的小块土地维持生活。

土豆恰恰就适合在这种人多地少的地方种植,满足人们的温饱。于是,爱尔兰农民就把他们的土地分成两块,一块种土豆,一块种小麦。小麦成熟后拿去交地租,而土豆留着自己吃。
这样一来,对于大部分爱尔兰农民来说,土豆几乎就是他们唯一的食物。爱尔兰人有句俗语:穷人的餐桌上有什么呢?除了大土豆就是小土豆。其实当时世界各地都是如此,哪个地方土豆多,哪个地方自然资源就匮乏,哪些人爱吃土豆,这些人就不是贵族。荷兰后印象派画家文森特·梵高有一幅画就是吃土豆的的人。如下图

吃土豆的的人——荷兰后印象派画家文森特·梵高
爱尔兰人依靠高产的土豆维持生活,另一方面,土豆保障了爱尔兰的粮食供应,又刺激人口不断增 长,这又进一步造成人多地少的状况,加剧了爱尔兰人对土豆的依赖。1821年,爱尔兰总共有680 万人。只过了20年,人口已经激增到将近820万了,
六,爱尔兰土豆大饥荒,物种单一培育的危害
土豆能让爱尔兰人免于饥饿,也给爱尔兰人埋下了巨大的隐患。首先是土豆的种植方式。我们通常吃的土豆,确切地说是土豆的块茎。

土豆块茎
在种小麦的时候,我们是将小麦的种子种到地里。而土豆既可以通过种子繁殖,也可以通过块茎发芽来繁殖。生物课上应该学过了,前者叫做有性繁殖,后者叫做无性繁殖。人们种土豆的时候,通常就是用无性繁殖,留一些土豆在地里不收,就算是留种了。
这种种植方式,就会造成一个问题,用块茎种出来的土豆,所有个体的基因都非常相近。在土豆的故乡南美洲,野生土豆有多达两百余种。可是被欧洲人带回来的只是极为稀少的品种,再一代代不停地种下去,结果就是整块农田,甚至整个国家的土豆基因都非常相近。爱尔兰几乎所有的土豆都属于同一个品种。

品种单一的农作物会更容易受到病虫害的影响。因为它们彼此都太相似了,如果有一个中招,那全部的土豆肯定也会跟着中招。这就是物种单一培育的危害。
1845年,这颗定时*弹炸**爆炸了,当时整个欧洲的土豆都遭受了一种"晚疫病”的侵害,它会造成土豆枯萎,块茎变黑而无法食用,于是大幅减产。

得了晚疫病的土豆
其他国家还好,爱尔兰受到的打击最大,因为爱尔兰只适合种植土豆,可现在种不了土豆,人口又因为土豆增加了这么多,小麦买不起,那普通的老百姓迅速陷入无粮可吃的地步。
你可能会说,他们难道没有存下来一些土豆吗?这就是土豆这个东西好的反面,土豆有一个很糟糕的特性,致使加重了灾害的影响。土豆是一种非常不耐储存的东西。因为土豆含水量非常大,切开土豆很容易感受到,刚刚从地里刨出来的土豆,含水量能达到75%以上。而小麦等作物收获时含水量还不到15%。

所以,你本来把土豆都挖出来储藏,可储藏的条件稍微差一点,豌就发芽了,发芽的土豆有龙葵素,是有毒的,不能吃,甚至干脆直接发霉,烂掉。而小麦放到仓库好几年都没问题。
因为土豆的这个特性,爱尔兰的农民就养成了随吃随挖的习惯,而不是先把土豆挖出来留着慢慢吃,他们也没什么储藏的技术,所以土豆一旦遭遇病害,地里的土豆迅速烂掉,而没有存量的农民,就立刻陷入饥荒。

问题还没完,这种土豆晚疫病的致病菌会侵入块茎,甚至污染土壤,这样一来,如果你把得了病毒的土豆留在田里,第二年新种的土豆依旧会得病,所以,此后几年,饥荒一直折磨着爱尔兰。
不过,爱尔兰人一直有向外移民的传统,因为岛屿国家,所以,大量无处求生的爱尔兰人只好逃离故土。在饥荒最为严重的1847年,就有25万爱尔兰人移民海外,到了1851年,爱尔兰人口只剩下655万人,短短十年减少了165万,半个世纪内,300万人离开了故土。

19-20世纪爱尔兰人口变化折线图
当时美国正在大力开发西部,需要大量的劳动力。于是,大量移居海外的爱尔兰人都到了美国。 这些爱尔兰移民到了美国之后,为了生存,往往只能去从事最脏最累的工作,还长期受到其他欧州移民的歧视和虐待,例如,修铁路这个最辛苦且很容易死在工程上的事情,都是黑人和爱尔兰人在做。

到达纽约的爱尔兰移民
可见,历史中,19世纪中期的爱尔兰土豆大饥荒同样印证了作物带来的繁荣是多么的脆弱,爱尔兰人曾依靠土豆这种作物,人口增长了17倍,养活了全国800万人口,空前的大饥荒席卷爱尔兰全境,1/4的爱尔兰人饥肠辘辘地死去。香蕉出问题可以不吃,咖啡出问题可以不喝,麦子和土豆出问题了该怎么办?
人类的创造物,人类的文化的产物反过来把人类钳制的死死的,一旦它们出了问题,我们跟着出问题,这就是人改变了自然环境后的反噬。我这还没说我们的更外部依存环境也就是太阳系和宇宙可能和已经出现的问题,我只是说地球内部物种生态多样性和基因的多样性的好处,或者说我们改变了多样性成为单一性的害处。
我们不仅要警惕动物病毒带给我们的灾难,更要重视植物病毒,防范植物病毒的最好办法是什么?保护生态的多样性,这样的话就不会出现一株玉米倒下,全部都倒下,一颗土豆烂掉,全部都烂掉的局面,正如中国的发展观中提到的:“绿水青山就是金山银山”